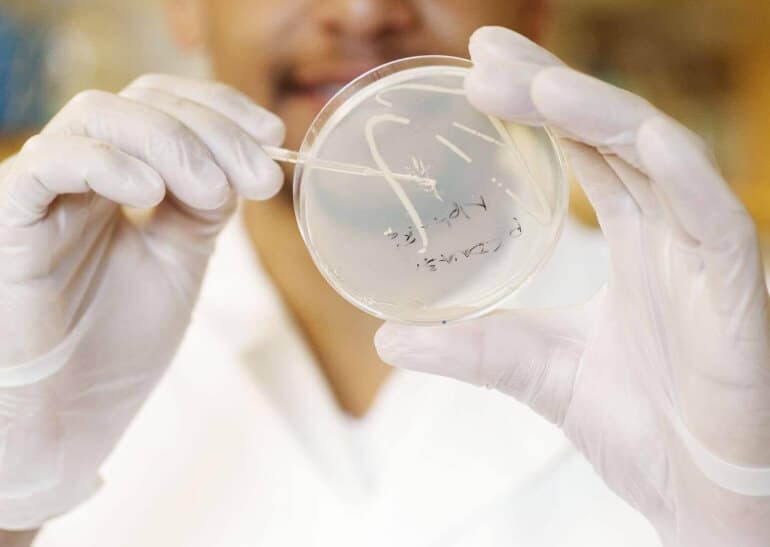

De fleste ordregivere gør det ikke, og mange ved ikke hvordan. Men man er som ordregiver forpligtet til at undersøge, om tilbud er afgivet i strid med konkurrencereglerne.
Når først udbudsprocessen er skudt i gang, er der mange krav og frister at holde styr på. Det er derfor naturligt, at ordregiver ikke har fokus på konkurrencereglerne og derfor kun får tjekket, om tilbuddene udbudsretligt kan accepteres.
Men ordregivere er forpligtet til også at undersøge, om tilbuddene er afgivet i strid med konkurrencereglerne. Det kan også være en god idé rent økonomisk.
Forpligtelse kan blive dyr for ordregiver
Som ordregiver kan man udelukke en tilbudsgiver, hvis man har ”tilstrækkelige plausible indikationer til at konkludere, at tilbudsgiveren har indgået en aftale med andre økonomiske aktører med henblik på konkurrencefordrejning”. Dette fremgår af en såkaldt frivillig udelukkelsesgrund i udbudsloven.
Hvis man har tilvalgt den frivillige udelukkelsesgrund, så er man forpligtet til at undersøge, om konkurrencereglerne umiddelbart er brudt.
De frivillige udelukkelsesgrunde er nogle, som ordregiveren tilvælger, og de gælder dermed ikke automatisk. Derfor kunne man fristes til at tro, at man som ordregiver bare kan lade være med at tilvælge udelukkelsesgrunden og dermed skøjte udenom en undersøgelse af, om konkurrencereglerne er overholdt.
Så nemt er det dog ikke.
Klagenævnet for Udbud har nemlig i sin praksis fastslået, at det følger af ligebehandlings- og gennemsigtighedsprincippet, at ordregivere, selvom den frivillige udelukkelsesgrund ikke aktivt er tilvalgt, i visse tilfælde har en undersøgelsespligt og dermed en pligt til at påse, at der ikke er ”køer på isen”.
Uanset om pligten følger af udbudsloven på den ene eller den anden måde, er der for ordregiver også et økonomisk incitament til at gå tilbuddene efter i sømmene. En tilbudskoordinering fjerner nemlig det konkurrenceelement, som ordregiver ønsker i en udbudsprocedure. Og når tilbudsgiverne ikke konkurrerer i samme omfang, som de ellers ville, så opnår ordregiveren heller ikke så fordelagtige tilbud, som man ellers ville. Ulovlig tilbudskoordinering blandt tilbudsgiverne kan derfor blive en dyr fornøjelse for ordregiver.
Bevisbyrden er lempet
Hvor meget skal der så til, før man skal udelukke en tilbudsgiver på grund af brud på konkurrencereglerne? Ordregivers bevisbyrde efter bestemmelsen er lempeligere end efter de øvrige frivillige udelukkelsesgrunde. Efter praksis fra Klagenævnet tilkommer der da også ordregiver et vist skøn ved vurderingen af, om der er sådanne indikationer, at det bør føre til udelukkelse.
Det er naturligt, at bevisbyrden er lempet, da ordregivere netop ikke er en konkurrencemyndighed, der skal holde øje med, om konkurrencereglerne er overholdt. Men det fratager ikke ordregiver sin undersøgelsespligt. Jo tyndere isen er, desto nemmere er det at falde igennem, og derfor medfører den lempede bevisbyrde også, at flere forhold kan udgøre sådanne plausible indikationer.
Omvendt, hvis den frivillige udelukkelsesgrund ikke er tilvalgt, og pligten derfor følger af ligebehandlings- og gennemsigtighedsprincippet, så er bevisbyrden tungere. Ifølge Klagenævnets praksis kræves der i så fald et mere sikkert grundlag for at antage, at konkurrencereglerne er overtrådt. Altså skal flere ting pege i retning af et brud på konkurrencereglerne, før ordregiver er forpligtet til at udelukke tilbudsgiveren. Ordregiver er dog også i nogen grad berettiget til at skønne forkert i sin vurdering af, hvornår der foreligger et sådant sikkert grundlag.
Tre ting bør vække mistanke
Tilbudsgiverne flager selvfølgelig ikke med, at de har koordineret tilbud, og det er derfor op til ordregiveren at gennemskue dette. Forskellige indikatorer kan pege i retning af ulovlig tilbudskoordinering:
Usædvanlig markedsadfærd kan være en indikator. Modtages der fx tilbud fra en virksomhed, som ikke ”normalt” afgiver tilbud i lignende udbudsprocedurer? En anden indikator kan være slå- og stavefejl, udtryk og bemærkninger, der går igen i materialet fra flere tilbudsgivere og dermed indikerer, at de har delt deres tilbudsmateriale med hinanden.
Begge opmærksomhedspunkter forelå i Klagenævnets seneste kendelse om tilbudskoordinering. Her havde de to vindende tilbudsgivere delt tilbudsmateriale, hvilket blandt andet kom til udtryk ved, at der var identiske slå- og stavefejl i tilbuddene. Samtidig var den ene virksomhed ikke en ”normal” tilbudsgiver på markedet for de udbudte produkter. Klagenævnet fastslog på denne baggrund, at der i sagen forelå så plausible indikationer, at ordregiveren skulle have udelukket de to tilbudsgivere.
Et yderligere forhold, som bør give anledning til et løftet øjenbryn, er, hvis to tilbudsgivere, der er kendte aktører på markedet og normalt konkurrenter, afgiver tilbud sammen. Hovedreglen er, at hvis en tilbudsgiver selv kan byde på opgaven, så må virksomheden ikke samarbejde med en konkurrent.
Som sagt er ordregiver ikke ubetinget forpligtet til at skønne korrekt i sin vurdering af, hvad der udgør henholdsvis tilstrækkelige plausible indikationer og et mere sikkert grundlag for en overtrædelse af konkurrencereglerne. Men det skal undersøges, og undersøgelsen kan falde ud på to måder; enten viser den, at der er ugler i mosen, eller også er man klar til at svømme videre. I det tilfælde, hvor undersøgelsen faktisk viser, at der er noget mistænkeligt i tilbuddet, har man som ordregiver en pligt til at reagere på det. Som udgangspunkt skal de koordinerende tilbudsgivere udelukkes.
Anders Birkelund Nielsen er partner i Bech-Bruun Advokatpartnerselskab
Denne kommentar er opindeligt bragt på Kommunen.dk.
Tekst, grafik, billeder, lyd og andet indhold på dette website er beskyttet efter lov om ophavsret. DK Medier forbeholder sig alle rettigheder til indholdet, herunder retten til at udnytte indholdet med henblik på tekst- og datamining, jf. ophavsretslovens §11 b og DSM-direktivets artikel 4.
Kunder med IP-aftale/Storkundeaftaler må kun dele DK Indkøbs artikler internt til brug for behandling af konkrete sager. Ved deling af konkrete sager forstås journalisering, arkivering eller lignende.
Kunder med personligt abonnement/login må ikke dele DK Indkøbs artikler med personer, der ikke selv har et personligt abonnement på DK Indkøb
Afvigelse fra ovenstående kræver skriftligt tilsagn fra DK Medier.